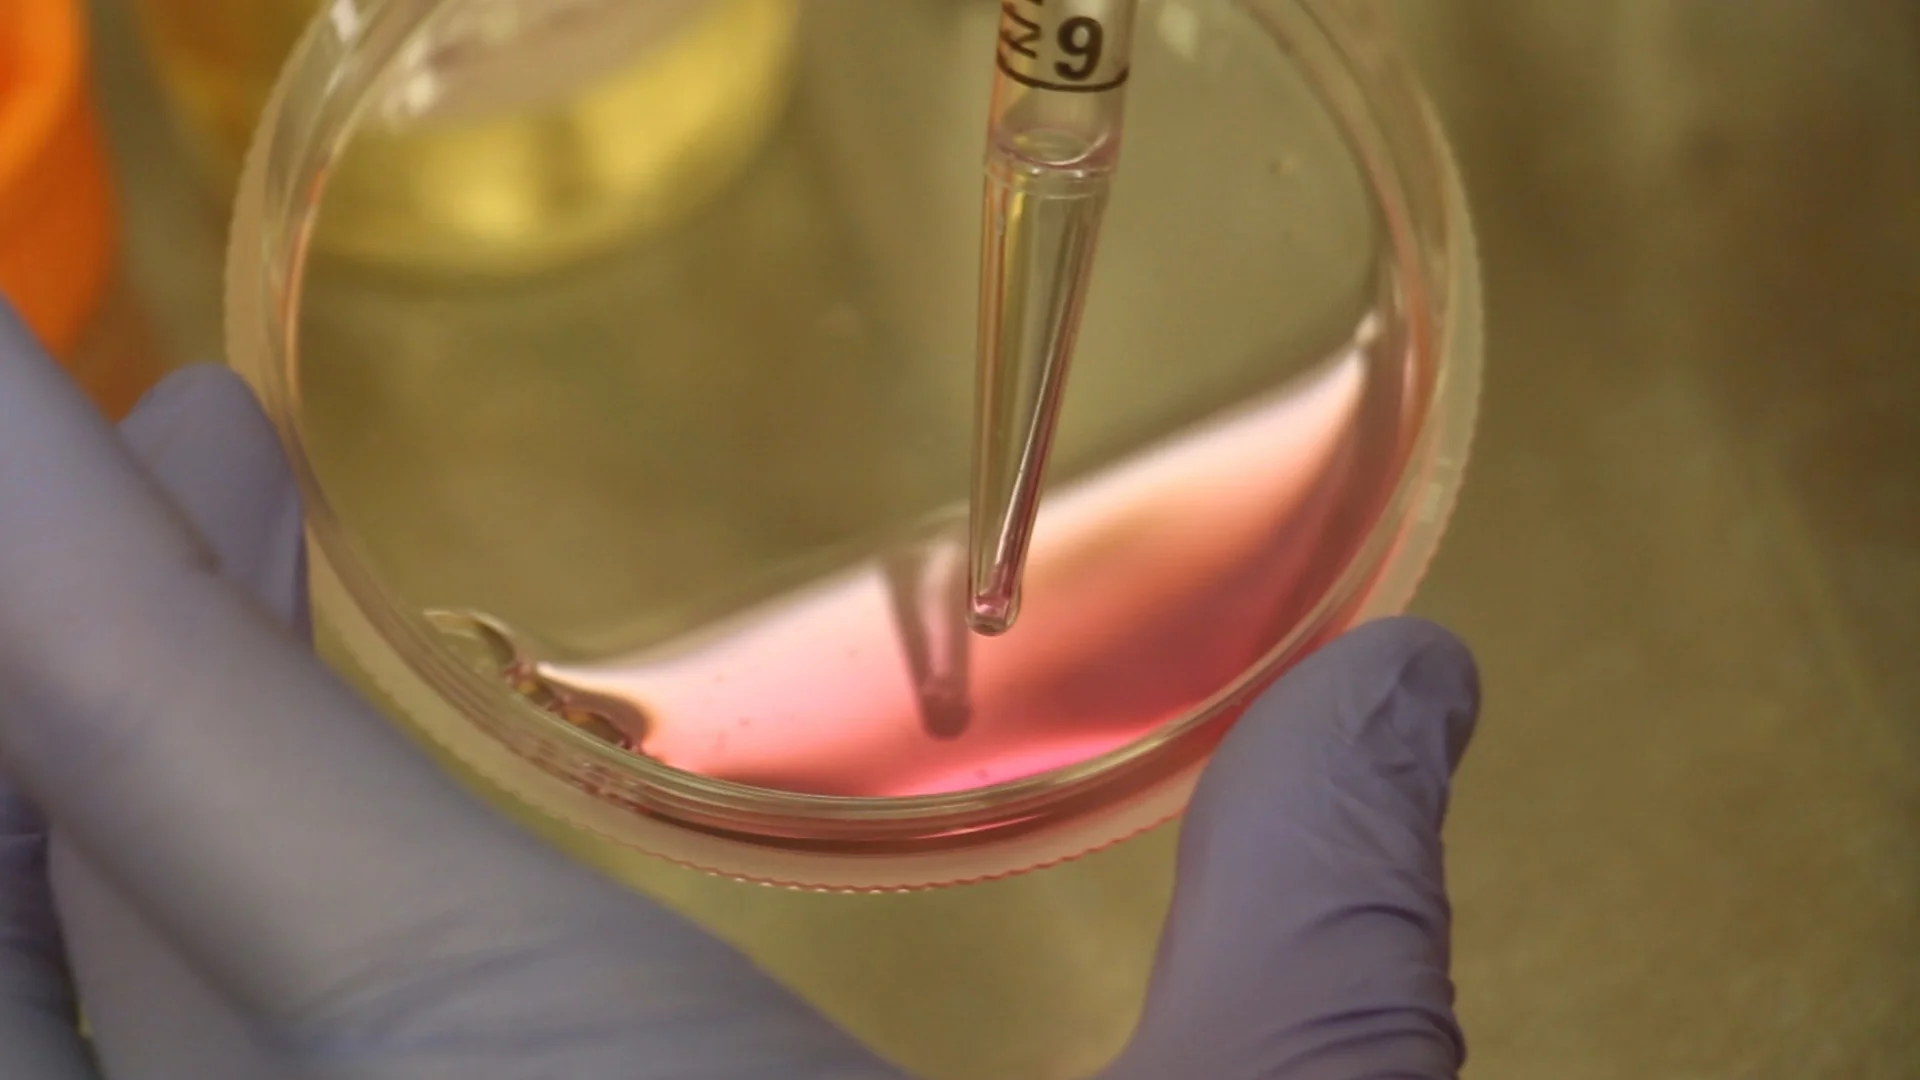

Science
In December 2024 I graduated with my PhD after spending 4.5 years in Dr. Mike Zhang’s nanoparticle vaccine lab. I’m interested in the structural biology of the immune system, especially as it relates to antigen processing and presentation. Now, I am a visiting scientist in Jeremy Brown’s phylogenetics lab at Louisiana State University, focusing on human-Hepatitis A coevolution.
Before grad school, I was an industrial engineer in a makeup factory. I also spent a few years maintaining lab equipment, testing course materials, and making microbiology lab tutorial videos for North Carolina State University’s Biotechnology program. Before that, I did software documentation for the Human Factors group at Idaho National Lab.
Cathepsin S
The cysteine protease cathepsin S is most famous for cutting proteins into pieces small enough for your immune system to learn to fight, an early step in the creation of new antibodies. In addition to digesting antigens in immune cells, cathepsin S has a very diverse set of jobs throughout the body. It protects your joints, it ages your skin, it activates receptors in blood vessels to tell them to form plaques, it can protect you from cancer or help tumors grow. Unlike most proteases in the same family, it can work across a wide pH range. My first paper about this is out in Biochemistry.
Poster about my preliminary peptide digest study, presented at Immunology 2023 in Washington, DC
Cover article about the pH-dependent specificity of Cathepsin S (Biochemistry) doi: 10.1021/acs.biochem.5c00287
Still from a video on colony picking
OLDER SELECTED WORKS
“Circular Construction in Prague” R DeHority, C Freling, A Ogunyoila, J Pagaduan, K Winterboer. (Chapter of Transforming Inclusive Circular Economies white paper, Pyxera Global, 2021)
"MVP sedimentation analysis fails to sufficiently mitigate water quality impacts within the Jefferson National Forest" (SPI-DAC comment to US Forest Service, 2020, used as key evidence in a successful federal lawsuit by the Sierra Club)
"A Direct Chemical Injection System for Agricultural Sprayers" (Second place winner of the 2017 AGCO National Student Design Competition)
"Using QIIME to Interpret Environmental Microbial Communities in an Upper Level Metagenomics Course" Julia Stevens, Riley DeHority, Carlos Goller. (CourseSource, 2017)
Educational Videos
NC State Biotechnology Program Video Series (director, 2014-2017)
45 videos with over 496,000 views total
Seen in 160 different countries and every US state
Applied for and received grants 2 years in a row to caption the videos for accessibility
Used in all NCSU Biotech classes
Incorporating Human Factors Into Product Design and Testing (2016) (American Society of Agricultural and Biological Engineers Ethics Video Challenge)
Quantitative Insights Into Microbial Ecology (QIIME) Video Tutorials
Still from a video on aseptic cell culture techniques